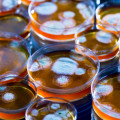

Լրահոս
 Ի՞նչ կա Լուսնի հակառակ կողմում՝ խավա՞ր, թե՞ պայծառ լույս
Ի՞նչ կա Լուսնի հակառակ կողմում՝ խավա՞ր, թե՞ պայծառ լույս
 Գիտե՞ք, թե իրականում ինչո՞ւ են սպիտակում ձեր մազերը
Գիտե՞ք, թե իրականում ինչո՞ւ են սպիտակում ձեր մազերը
 Խայամի քառյակների առեղծվածը. ի՞նչ են նշանակում «սիրելին» ու «գինին»
Խայամի քառյակների առեղծվածը. ի՞նչ են նշանակում «սիրելին» ու «գինին»
 Երկնաքերից մարդու գլխին ընկած մետաղադրամի հետևանքները
Երկնաքերից մարդու գլխին ընկած մետաղադրամի հետևանքները
 Սև թեյի հետևանքները ատամների առողջության վրա
Սև թեյի հետևանքները ատամների առողջության վրա
 Ո՞րն է աշխարհի ամենամեծ ու ամենաջրառատ ջրվեժը, եթե դա ո՛չ Նիագարան է, ո՛չ Անխելը, ո՛չ էլ Վիկտորիան
Ո՞րն է աշխարհի ամենամեծ ու ամենաջրառատ ջրվեժը, եթե դա ո՛չ Նիագարան է, ո՛չ Անխելը, ո՛չ էլ Վիկտորիան
 Ինչո՞ւ կատուն չի վնասվում բարձրությունից ընկնելիս
Ինչո՞ւ կատուն չի վնասվում բարձրությունից ընկնելիս
 Ատոմների, տիեզերքի ու դատարկության մասին ուշագրավ փաստեր
Ատոմների, տիեզերքի ու դատարկության մասին ուշագրավ փաստեր
 Իսկ դուք գիտե՞ք, թե ինչպես են մեղուները բզզում և ինչո՞ւ
Իսկ դուք գիտե՞ք, թե ինչպես են մեղուները բզզում և ինչո՞ւ
 Ինչպե՞ս է Չինական մեծ պարիսպը երևում Լուսնից
Ինչպե՞ս է Չինական մեծ պարիսպը երևում Լուսնից
 Արյունը միշտ չէ, որ կարմիր է. իսկ ո՞ւմ արյունն է կապույտ կամ թափանցիկ
Արյունը միշտ չէ, որ կարմիր է. իսկ ո՞ւմ արյունն է կապույտ կամ թափանցիկ
 Հակաբիոկների «նախահայրը»՝ բորբոս թաց թամբերից ու լծասարքերից
Հակաբիոկների «նախահայրը»՝ բորբոս թաց թամբերից ու լծասարքերից
 Առաջին տիեզերագնաց կենդանին ամենևին էլ շունը չէ, այլ...
Առաջին տիեզերագնաց կենդանին ամենևին էլ շունը չէ, այլ...
 Ինչպե՞ս քնել առողջ լինելու համար. ա՞ջ, ձա՞խ կողքի, թե՞ մեջքի վրա
Ինչպե՞ս քնել առողջ լինելու համար. ա՞ջ, ձա՞խ կողքի, թե՞ մեջքի վրա
 Հավատարմության գոտի. առասպե՞լ, թե՞ իրականություն
Հավատարմության գոտի. առասպե՞լ, թե՞ իրականություն
 Ամեն ինչ գիտե՞նք Կոլումբոսի մասին. իրականում ոչինչ էլ չգիտենք (Տեսանյութ)
Ամեն ինչ գիտե՞նք Կոլումբոսի մասին. իրականում ոչինչ էլ չգիտենք (Տեսանյութ)
 Ամեն ինչ գիտե՞նք Կոլումբոսի մասին. իրականում ոչինչ էլ չգիտենք
Ամեն ինչ գիտե՞նք Կոլումբոսի մասին. իրականում ոչինչ էլ չգիտենք
 Ղրիմի «նվիրումը»՝ 15 րոպեում. ի՞նչ կապ ունի Խրուշչովը (Տեսանյութ)
Ղրիմի «նվիրումը»՝ 15 րոպեում. ի՞նչ կապ ունի Խրուշչովը (Տեսանյութ)
 Ղրիմի «նվիրումը»՝ 15 րոպեում. ի՞նչ կապ ունի Խրուշչովը
Ղրիմի «նվիրումը»՝ 15 րոպեում. ի՞նչ կապ ունի Խրուշչովը
 Աշխարհում «ձուկ» հասկացություն գոյություն չունի
Աշխարհում «ձուկ» հասկացություն գոյություն չունի
 Չկա այնպիսի մեկը, որն ալկոհոլ չի օգտագործում
Չկա այնպիսի մեկը, որն ալկոհոլ չի օգտագործում
 Ո՞վ է իրականում «երկաթյա վարագույր» արտահայտության հեղինակը
Ո՞վ է իրականում «երկաթյա վարագույր» արտահայտության հեղինակը
 Ի՞նչ է նշանակում SOS փրկության ազդանշանը. պարզվում է՝ ոչինչ
Ի՞նչ է նշանակում SOS փրկության ազդանշանը. պարզվում է՝ ոչինչ
 Ե՞րբ մարդկությունը կհասնի աստղերին. «խանգարողն» էլի Էյնշտեյնն է
Ե՞րբ մարդկությունը կհասնի աստղերին. «խանգարողն» էլի Էյնշտեյնն է
 Էվոլուցիա՞, թե դեգրադացիա. ի՞նչ է մեզ «սպառնում»
Էվոլուցիա՞, թե դեգրադացիա. ի՞նչ է մեզ «սպառնում»
 Շախմատի ու քաղաքականության ուղիղ կապը. ինչո՞ւ «վեզիրը» դարձավ «թագուհի»
Շախմատի ու քաղաքականության ուղիղ կապը. ինչո՞ւ «վեզիրը» դարձավ «թագուհի»
 Պիզայի աշտարակն ամենևին էլ ամենաթեքը չէ
Պիզայի աշտարակն ամենևին էլ ամենաթեքը չէ
 Իսկական «ոդիսական». ո՞վ է եղել Հոմերոսը և եղե՞լ է արդյոք ընդհանրապես
Իսկական «ոդիսական». ո՞վ է եղել Հոմերոսը և եղե՞լ է արդյոք ընդհանրապես
 Գիտե՞ք, թե իրականում ինչո՞ւ են սպիտակում ձեր մազերը
Գիտե՞ք, թե իրականում ինչո՞ւ են սպիտակում ձեր մազերը

 ԵԱ Երեւանում․ Հայաստանի Մ16 հավաքականի հաղթական մեկնարկը
ԵԱ Երեւանում․ Հայաստանի Մ16 հավաքականի հաղթական մեկնարկը
 Հրդեհ է բռնկվել Ստավրոպոլի ներկերի պահեստում
Հրդեհ է բռնկվել Ստավրոպոլի ներկերի պահեստում
 «Համահայկական ճակատ» շարժման տեղեկատվական կենտրոնի հաղորդագրությունը
«Համահայկական ճակատ» շարժման տեղեկատվական կենտրոնի հաղորդագրությունը Հնդկաստանը Պակիստանի ավելի քան 20 քաղաքացու ներառել է ահաբեկիչների ցուցակում
Հնդկաստանը Պակիստանի ավելի քան 20 քաղաքացու ներառել է ահաբեկիչների ցուցակում
 Թրամփը պնդում է, որ Նեթանյահուն «գիտի, թե ով է բոսը»
Թրամփը պնդում է, որ Նեթանյահուն «գիտի, թե ով է բոսը»
 Սպերցյանն արդեն բուժզննում է անցնում իր նոր ակումբ տեղափոխվելու համար
Սպերցյանն արդեն բուժզննում է անցնում իր նոր ակումբ տեղափոխվելու համար
 Հնդկաստանն էներգետիկ ճգնաժամը հաղթահարում է տարբեր երկրների հետ բարեկամության շնորհիվ. Մոդի
Հնդկաստանն էներգետիկ ճգնաժամը հաղթահարում է տարբեր երկրների հետ բարեկամության շնորհիվ. Մոդի
 Ֆրանսիայում Էբոլա տենդով առաջին հիվանդը դուրս է գրվել հիվանդանոցից
Ֆրանսիայում Էբոլա տենդով առաջին հիվանդը դուրս է գրվել հիվանդանոցից
 Հուլիսի 7-ին, 8-ին, 9-ին գազ չի լինելու
Հուլիսի 7-ին, 8-ին, 9-ին գազ չի լինելու
 Հուլիսի 6-ին և 7-ին լույս չի լինելու
Հուլիսի 6-ին և 7-ին լույս չի լինելու
 ԱՄՆ-ին և Իսրայելին «մոտալուտ հատուցում». Իրանի նոր հրամանատարի հայտարարությունը
ԱՄՆ-ին և Իսրայելին «մոտալուտ հատուցում». Իրանի նոր հրամանատարի հայտարարությունը
 Գեղամա լեռների հրաշքը․ Սուրենյանը տեսանյութ է հրապարակել
Գեղամա լեռների հրաշքը․ Սուրենյանը տեսանյութ է հրապարակել
 Օդի ջերմաստիճանը կնվազի 7 աստիճանով․ ի՞նչ եղանակ սպասել առաջիկա օրերին
Օդի ջերմաստիճանը կնվազի 7 աստիճանով․ ի՞նչ եղանակ սպասել առաջիկա օրերին
 ԱՄՆ-ի ջերմային ալիքները սպառնում են անկախության 250-րդ տարեդարձի իրադարձություններին և Աշխարհի առաջնությանը
ԱՄՆ-ի ջերմային ալիքները սպառնում են անկախության 250-րդ տարեդարձի իրադարձություններին և Աշխարհի առաջնությանը
 Դատարանը տապալեց իր սահմանադրական հիմնական մանդատը․ Ռոբերտ Ամստերդամ
Դատարանը տապալեց իր սահմանադրական հիմնական մանդատը․ Ռոբերտ Ամստերդամ Տաշիրի Սարատովկա գյուղում կարկուտը հողին է հավասարացրել ամեն ինչ․ տեսանյութ
Տաշիրի Սարատովկա գյուղում կարկուտը հողին է հավասարացրել ամեն ինչ․ տեսանյութ
 Արզամասի շրջանում ուժգին փոթորկի հետևանքով երեխա է զոհվել
Արզամասի շրջանում ուժգին փոթորկի հետևանքով երեխա է զոհվել
 ՌԴ ՊՆ-ն հայտարարել է, թե ինչ պայմաններում կարող են նոր հարվածներ հասցվել Ուկրաինային
ՌԴ ՊՆ-ն հայտարարել է, թե ինչ պայմաններում կարող են նոր հարվածներ հասցվել Ուկրաինային
 Բասկետբոլի Հայաստանի Մ16 տարեկանների հավաքականը փայլուն հաղթանակով է մեկնարկել Եվրոպայի C դիվիզիոնի առաջնությունում
Բասկետբոլի Հայաստանի Մ16 տարեկանների հավաքականը փայլուն հաղթանակով է մեկնարկել Եվրոպայի C դիվիզիոնի առաջնությունում
 Պեսկովի կոշտ ուղերձը Զելենսկուն․ «Մոսկվան է մայրաքաղաքը, ոչ թե Կոնստանտինովկան»
Պեսկովի կոշտ ուղերձը Զելենսկուն․ «Մոսկվան է մայրաքաղաքը, ոչ թե Կոնստանտինովկան»
 Եղվարդում հեղեղ ու կարկուտ է
Եղվարդում հեղեղ ու կարկուտ է
 Ամբերդի վերականգնման աշխատանքներին ծանոթանալու նպատակով ԿԳՄՍ նախարարն այցելել է ամրոցի տարածք
Ամբերդի վերականգնման աշխատանքներին ծանոթանալու նպատակով ԿԳՄՍ նախարարն այցելել է ամրոցի տարածք
 Մենք մեր ողջ կյանքում ծառայել ենք Հայաստանի Հանրապետությանը, ոչ թե ձեր նման` զբաղվել բամբասանքով․ Արսեն Վարդանյան
Մենք մեր ողջ կյանքում ծառայել ենք Հայաստանի Հանրապետությանը, ոչ թե ձեր նման` զբաղվել բամբասանքով․ Արսեն Վարդանյան Սահմանադրական դատարանի այս որոշումը ոչ թե պայքարի ավարտն է, այլ նոր՝ ավելի համակարգված, ինստիտուցիոնալ և լայնածավալ քաղաքական դիմադրության փուլի սկիզբը․ «Ուժեղ Հայաստան»
Սահմանադրական դատարանի այս որոշումը ոչ թե պայքարի ավարտն է, այլ նոր՝ ավելի համակարգված, ինստիտուցիոնալ և լայնածավալ քաղաքական դիմադրության փուլի սկիզբը․ «Ուժեղ Հայաստան» «Արարատ-Արմենիա»-ի եվրագավաթի հայտացուցակը և մեկնարկային կազմը
«Արարատ-Արմենիա»-ի եվրագավաթի հայտացուցակը և մեկնարկային կազմը
 Զելենսկին Մերցի հետ քննարկել է Patriot-ի հրթիռների մատակարարումները
Զելենսկին Մերցի հետ քննարկել է Patriot-ի հրթիռների մատակարարումները
 Փաշինյանն այցելել է Վեդիի ջրամբար և Արարատի մարզի մի քանի բնակավայրերում ծանոթացել իրականացվող ծրագրերի ընթացքին
Փաշինյանն այցելել է Վեդիի ջրամբար և Արարատի մարզի մի քանի բնակավայրերում ծանոթացել իրականացվող ծրագրերի ընթացքին
 Ինչպես կարձագանքի Զելենսկին Կոնստանտինովկայի կորստին. DW
Ինչպես կարձագանքի Զելենսկին Կոնստանտինովկայի կորստին. DW
 ՍԴ-ն հաստատեց ԿԸՀ որոշումը․ Ազգային ժողովում կլինի երեք խմբակցություն
ՍԴ-ն հաստատեց ԿԸՀ որոշումը․ Ազգային ժողովում կլինի երեք խմբակցություն
 Ռոստովում մակական հարձակվել է երեխայի վրա
Ռոստովում մակական հարձակվել է երեխայի վրա
 Իսրայելի գործողությունների հետևանքով Գազայում զոհերի թիվը գերազանցել է 73 հազարը
Իսրայելի գործողությունների հետևանքով Գազայում զոհերի թիվը գերազանցել է 73 հազարը
 Տարադրամի փոխարժեքները հուլիսի 4-ին
Տարադրամի փոխարժեքները հուլիսի 4-ին
 Ինչպիսի՞ եղանակ է սպասվում հանրապետությունում
Ինչպիսի՞ եղանակ է սպասվում հանրապետությունում
 Կապան-Խոտանան ավտոճանապարհին ավտովոզում բռնկված հրդեհի հետևանքով ավտովոզը և 5 ավտոմեքենաներ այրվել են
Կապան-Խոտանան ավտոճանապարհին ավտովոզում բռնկված հրդեհի հետևանքով ավտովոզը և 5 ավտոմեքենաներ այրվել են
 Հայտնի է դարձել Իրանի և ԱՄՆ-ի հաջորդ բանակցությունների ամսաթիվը
Հայտնի է դարձել Իրանի և ԱՄՆ-ի հաջորդ բանակցությունների ամսաթիվը
 Վլադիմիր Սարուխանյանը՝ IBA Nomad 15 մրցաշարի հաղթող
Վլադիմիր Սարուխանյանը՝ IBA Nomad 15 մրցաշարի հաղթող
 Ստամբուլ–Միներալնիե Վոդի չվերթը տագնապի ազդանշան է տվել և վերադարձել է օդանավակայան
Ստամբուլ–Միներալնիե Վոդի չվերթը տագնապի ազդանշան է տվել և վերադարձել է օդանավակայան
 ՍԴ-ից այլ բան չէինք ակնկալում. «Համահայկական ճակատ» կուսակցության ղեկավար Արսեն Վարդանյան
ՍԴ-ից այլ բան չէինք ակնկալում. «Համահայկական ճակատ» կուսակցության ղեկավար Արսեն Վարդանյան Սահմանադրական դատարանը մերժեց ԱԺ ընտրությունների արդյունքներն անվավեր ճանաչելու 7 ուժերի դիմումները եւ թողեց ԿԸՀ որոշումն անփոփոխ․ Գոհար Մելոյան
Սահմանադրական դատարանը մերժեց ԱԺ ընտրությունների արդյունքներն անվավեր ճանաչելու 7 ուժերի դիմումները եւ թողեց ԿԸՀ որոշումն անփոփոխ․ Գոհար Մելոյան Արեգակի վրա ինը ուժեղ բռնկում է եղել
Արեգակի վրա ինը ուժեղ բռնկում է եղել
 Ինչպես և սպասվում էր, ՀՀ Սահմանադրական դատարանը, դակեց Նիկոլ Փաշինյանի պատվերը` հափշտակելով Ազգային ժողովի մանդատների ⅗-րդը, իրականացնելով ժողովրդի իշխանության բռնազավթում․ «ՀայաՔվե»
Ինչպես և սպասվում էր, ՀՀ Սահմանադրական դատարանը, դակեց Նիկոլ Փաշինյանի պատվերը` հափշտակելով Ազգային ժողովի մանդատների ⅗-րդը, իրականացնելով ժողովրդի իշխանության բռնազավթում․ «ՀայաՔվե» Կոստանտինովկան մերն է, և եթե Զելենսկին պատրաստ է, թող գա Մոսկվա․ Պեսկով
Կոստանտինովկան մերն է, և եթե Զելենսկին պատրաստ է, թող գա Մոսկվա․ Պեսկով
 Կիևյան կամուրջի աշխատանքները շարունակվում են ամենօրյա ռեժիմով, նույնիսկ՝ հանգստյան օրերին. Կարապետյան
Կիևյան կամուրջի աշխատանքները շարունակվում են ամենօրյա ռեժիմով, նույնիսկ՝ հանգստյան օրերին. Կարապետյան
 Նրա էգոն հավաքականին պատանդ է պահում․ Իբրահիմովիչը քննադատել է Ռոնալդուին
Նրա էգոն հավաքականին պատանդ է պահում․ Իբրահիմովիչը քննադատել է Ռոնալդուին
 Ռուսաստանը հարվածել է Զապորոժիեի մարզում ուկրաինական նավթամբարի
Ռուսաստանը հարվածել է Զապորոժիեի մարզում ուկրաինական նավթամբարի
 Քիչ անց կմեկնարկի «Հարավային Կովկասի էներգետիկ անվտանգությունը. Հայաստանի ընտրությունը». միջազգային գիտափորձագիտական կոնֆերանսը
Քիչ անց կմեկնարկի «Հարավային Կովկասի էներգետիկ անվտանգությունը. Հայաստանի ընտրությունը». միջազգային գիտափորձագիտական կոնֆերանսը Մի քանի ժամ ընդհատվել է «Հայոց պատմություն» և «Ֆիզիկա» առարկաների քննության գնահատականների բողոքարկման գործընթացը
Մի քանի ժամ ընդհատվել է «Հայոց պատմություն» և «Ֆիզիկա» առարկաների քննության գնահատականների բողոքարկման գործընթացը
 Քաղաքացիները համաձայն չեն ընտրությունների արդյունքներին
Քաղաքացիները համաձայն չեն ընտրությունների արդյունքներին
 Հայաստանի և Ռուսաստանի միջև էներգետիկ ոլորտում փոխգործակցությունը կշարունակվի. ռուս դիվանագետ
Հայաստանի և Ռուսաստանի միջև էներգետիկ ոլորտում փոխգործակցությունը կշարունակվի. ռուս դիվանագետ
Շնորհավոր ծնունդդ, լավ հայ. քեզ միշտ հիշելու ենք՝ սիրով ու ժպիտով. Մհեր Ավետիսյան
Շնորհավոր ծնունդդ, լավ հայ. քեզ միշտ հիշելու ենք՝ սիրով ու ժպիտով. Մհեր Ավետիսյան 

1
Կյանքից անժամանակ հեռացել է Ռոմելա Սարգսյանը
2
Տղամարդը փորձել է ածելիով կտրել կնոջ սեռական օրգանները
3
Հուլիսի 1-ից ջրամատակարարման գրաֆիկները փոփոխվում են․ մանրամասներ
4
Վերջին անգամ նման երևույթ Հայաստանում գրանցվել է 2009թ-ին. Սուրենյանը տեսանյութ է հրապարակել
5
14-ամյա աղջիկը սեփական կյանքի գնով փրկել է իր կրտսեր եղբորը




